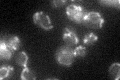
YBR227C
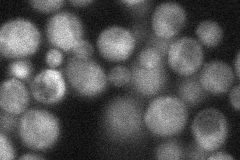
YBR227C

View description
Mitochondrial matrix protein; putative ATP-binding chaperone with non-proteolytic function; similar to bacterial ClpX proteins
Localization:
Intensity:
Fold change:
Significance:
-
C’ GFP library in SD
mitochondria34.21 -
N' NOP1pr-GFP in SD

mitochondria130.126 -
N' TEF2pr-mCherry in SD

mitochondria98.2162 -
N' NATIVEpr-GFP in SD
cytosol,punctate37.0573 -
N' TEF2pr-VC and Cyto-VN in SD

#N/A0 -
C’ GFP library in SD+DTT

mitochondria41.11.2No -
C’ GFP library in SD+H2O2

mitochondria32.270.94No -
C’ GFP library in Starvation Media

mitochondria35.171.02No -
C’ GFP library on the background of Pup2-DaMP

mitochondria -
C’ GFP library on the background of CCT mutant

mitochondria41.10911.20165No
